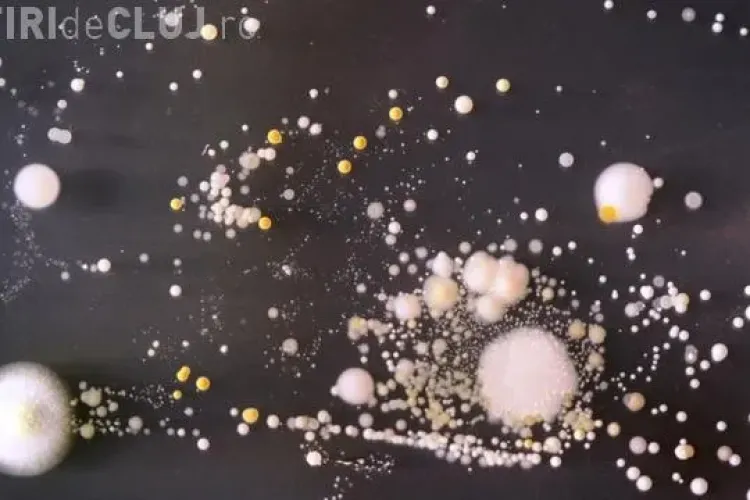
Folosești în permanență telefonul mobil? Vezi aici cât de ”murdar” e cu adevărat

Francezii interzic ținutele musulmane la plajă, în mai multe orașe din țară. Femeile nu mai au voie să poarte ”burkini”
Francezii au decis să interzică potrul costumelor de baie tip ”burkini” în 15 orașe din țară, aceștia evocând îngrijorările ulterioare atacurilor teroriste care au avut loc în ţară.
O femeie care purta burkini pe plajă a fost amendată de poliție - FOTO
O femeie a fost amendată pe o plajă din Nisa, pentru că purta un burkini (costumul de baie conceput pentru musulmance). Ba mai mult a fost amenințată cu sparay -ul, dacă nu se conformează.
ATENTAT LA MUNCHEN. Sunt cel puţin 9 morţi - VIDEO
Atentatul terorist de la Munchen s-a soldat cu cel puțin nouă morţi.
Un român, dat dispărut în urma atentatului de la Nisa, a fost descoperit mort. Soția și fiul său au fost răniți
Un român, Cristian Coman, dat dispărut în urma atentatului de la Nisa, în care cel puțin 84 de persoane și-au pierdut viața, a fost identificat, marți dimineață, însă din păcate acesta era decedat, potrivit MAE.
Atentatul de la Nisa, revendicat de ISIS
Masacrul de la Nisa a fot revendicat de către ISIS, a anunțat, sâmbătă dimineață, o agenție de presă afiliată grupării teroriste.
Cine este autorul atentatului de la Nisa! Ce ştiu anchetatorii despre el
Șoferul camionului care a omorât 84 de persoane, joi, 14 iulie, la un spectacol de artificii cu ocazia Zilei Naţionale a Franţei a fost identificat.
Atentat la Nisa! Un motociclist a încercat EROIC să-l oprească pe șoferul camionului
Un motociclist a încercat într-un gest eroic de a-l opri pe șoferul camionului care a ucis 84 de oameni, joi noapte, la Nisa.
Doi români au fost răniți în atentatul de la Nisa. Ce spune MAE
Potrivit unui comunicat al Ministerului Afacerilor Externe, doi cetățeni români au fost răniți în atentatul de aseară de la Nisa, Franța.
MASACRU în Franța, chiar de ziua națională! Zeci de persoane au fost ucise, printre care și copii
Cel puțin 80 de morți, printre care și copii, au rezultat în urma unui masacru ce a avut loc aseară la Nisa, Franța.
Programul meciurilor din optimile EURO 2016. Când joacă echipele rămase în competiție
Ultimele meciuri din cadrul Grupelor Campionatului Eurpean de Fotbal, din Franța, au avut loc miercuri, fiind astfel desemnate ultimele 16 echipe rămase în competiție.
La Euro 2016 au fost interzise băuturile alcoolice în apropierea stadioanelor
Guvernul francez a decis să fie interzisă vânzarea de băuturi alcoolice în jurul stadioanelor cu risc, după valul de violenţe dintre suporteri.
Programul complet al EURO 2016. Vezi când se joacă meciurile
Turneul final al Campionatului European de Fotbal va începe pe 10 iunie, primul meci fiind cel al României cu Franța.
Hexi Pharma: Am tăcut destul! Reacţie în scandalul dezinfectanţilor. Profită producătorii externi și unele ”persoane”
Reprezentanții Hexi Pharma au deci să rupă tăcerea și să combată acuzațiile care li se aduc.
Florian Walter poate fi găsit acum și în gaură de șarpe. Ce decizie au luat judecătorii
Florian Walter s-ar ascunde în Cuba, dar judecătorii au luat o decizie prin care ar putea fi găsit și recuperat.
Clujenii de la Farmec și-au deschis magazin de brand în Franța FOTO (P)
Compania clujeană Farmec, alături de partenerul Carlgin Sasu, deschide primul magazin de brand din Franța, la Menton, una dintre cele mai cunoscute stațiuni de pe Coasta de Azur, situată la 40 de km est de Nisa.
Unde a fugit Florian Walter nu îl mai prinde nimeni. Ce destinație ar fi ales milionarul
Florian Walter, acuzat de DIICOT de mari manevre financiare, ar fi fugit din România, destinația fiind una din care va fi dificilă recuperarea.
Tarom vinde bilete de la 99 euro pentru toate destinaţiile externe operate
Tarom vine în perioada 2 - 15 februarie bilete pentru toate destinaţiile externe deservite la preţuri care pornesc de la 99 euro, pentru o călătorie dus-întors.
Jazz la Opera Maghiară din Cluj. Este omagiat KŐRÖSSY JANCSI
Opera Maghiară din Cluj va găzdui sâmbătă, 20 decembrie 2014, de la ora 19.00, SEARA OMAGIALĂ KŐRÖSSY JANCSI.
Meciul Steaua - Petrolul a făcut zero audiență pe Look TV! Se măsoară bine audiențele?
Meciul Steaua - Petrolul, 3-2, disputat duminică, 21 septembrie, a avut o audiență zero în București, conform măsurătorilor.
Billy Idol cântă pe Cluj Arena! Cât costă biletele
Legenda rock Billy Idol va cânta pe Cluj Arena, în 30 iunie, la o zi după concertul din București.
Pacos Ferreira a confundat Clujul și a aterizat în altă ȚARĂ pentru meciul cu Pandurii de pe Cluj Arena
Portughezii de la Pacos Ferreira au confundat Romania cu altă țară și au zburat direct acolo.
Care sunt firmele de asigurări cu cele mai multe plângeri la ASF
Circa 10.000 de persoane au depus în primele nouă luni ale anului plângeri față de cele mai mari nouă companii din piaţa asigurărilor generale din România.
Ryanair se mută la Cluj, după finalizarea noii pistei Aeroportului. Cine declară?
Președintele Consiliului Județean Cluj, Horea Uioreanu, a declarat, joi seara, la Știri de Cluj că după finalizarea noii piste a Aeroportului Internațional Cluj o nouă companie aeriană low-cost se va muta la Cluj.
Fiță de vedetă? Vezi cum călătorește Mihaela Rădulescu la Monaco
Mihaela Rădulescu și-a uimit fanii cu o fotografie postată pe Facebook, în care le arată cum reușește ea să evite aglomerația din trafic.
O firmă angajează numai oameni frumoşi: ”Rugăm urâţii să NU trimită CV-uri”
Un site de joburi solicită numai persoanelor frumoase să trimită CV -uri, iar restul să se abțină.
Napoca Jazz, Blues & Wine Festival - Jazz de calitate la Cluj-Napoca în perioada 15 - 19 mai
Napoca Jazz, Blues & Wine Festival se anunță a fi un eveniment de calitate, care va avea loc în perioada 15 - 19 mai, la Cluj-Napoca.
Folosești în permanență telefonul mobil? Vezi aici cât de ”murdar” e cu adevărat
O echipă de studenți de microbiologie a realizat o serie de fotografii microscopice în care sunt prezentate bacteriile prezente pe telefoanele mobile.
Fosilele UNICE în Europa, găsite de un cercetător clujean, donate Muzeului Ardelean din Cluj-Napoca
Fosilele pterozaurului găsite la Sebeş-Glod, judeţul Alba, de un cercetător clujean au fost donate Societăţii Muzeului Ardelean din Cluj-Napoca. Acestea vor putea fi cercetate studiate.
Târg de joburi la Cluj, organizat de un preot. Tinerii, momiți cu salarii de 500 de euro, dar firmele nu s-au înghesuit
Sute de tineri clujeni s-au grăbit astăzi să meargă la Casino-ul din Parcul Central din Cluj, sperând să-și găsească un loc de muncă. Din păcate, însă, firmele nu au fost foarte interesate să recruteze tineri.